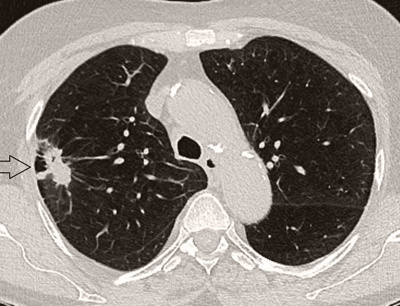
Hirslanden-Computertomografie-ohne-hohe-Strahlenbelastung-1

In der Radiologie Hirslanden Zürich wird das gesamte Spektrum der diagnostischen bildgebenden Verfahren angeboten.
Die Nuklearmedizin ermöglicht zusätzlich auch Funktionsuntersuchungen der Organe.
Wir investieren laufend in neue Technologien und verfügen über Geräte der allerneuesten Generation.
Der Einsatz modernster Diagnostikgeräte bietet Ihnen nennenswerte Vorteile:
- Hervorragende Bildqualität bei extrem kurzen Untersuchungszeiten
- Detaillierte Untersuchungsverfahren mit geringer Strahlenbelastung
- Minimalinvasive diagnostische und therapeutische Eingriffe werden direkt im Institut durchgeführt
Eine Patientenbetreuung steht Ihnen vor und nach der Untersuchung zur Verfügung.
Radiologie Hirslanden Zürich
+41 44 387 26 35